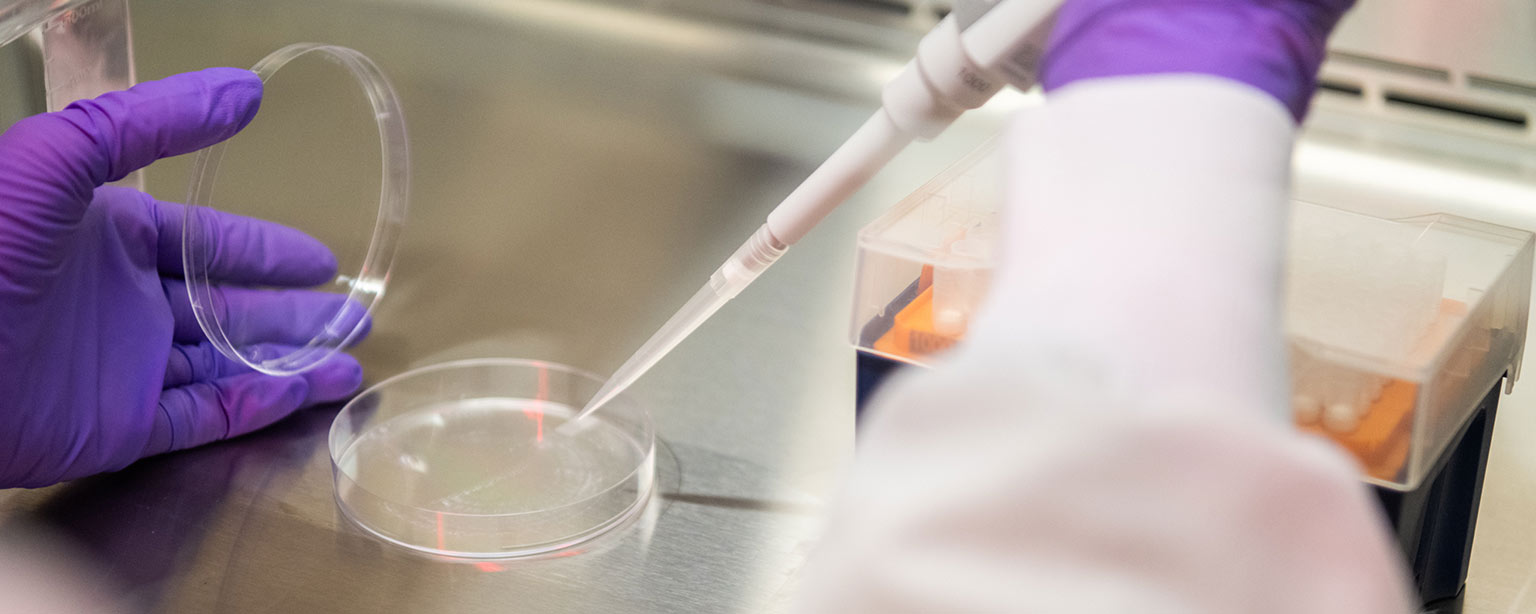
Phd In Health Sciences Engineering Icahn School Of Medicine

Phd In Health Sciences

Ph D Health Sciences Seton Hall University Find the best phd programmes in the field of health sciences from top universities worldwide. check all 587 programmes. A collaboration between the school of health professions and the graduate school of biomedical sciences, the phd in health sciences is designed to prepare allied health professionals to assume major leadership, research and educational positions within their professions, as well as to provide career advancement opportunities.

Phd In Environmental Health Sciences School Of Public Health Health Forbes advisor analyzed experiences and outcomes at 44 schools to find the best online ph.d. in health science and doctor of health science programs. The ph.d. program in health sciences (hs) provides opportunities for specialized expertise across several concentration areas: applied aging and rehabilitation science, audiology & speech language pathology, and behavioral analysis. Learn how to become a leader in health sciences with an online phd program that combines education, research and practice. explore the curriculum, tuition, faculty and career opportunities of this interdisciplinary program. The doctor of philosophy (phd) in population health sciences (phs) is a cohort based, multidisciplinary degree that provides students with the research and analytical tools needed to tackle a wide range of complex, large scale public health issues.

Phd Health Sciences University Of York Learn how to become a leader in health sciences with an online phd program that combines education, research and practice. explore the curriculum, tuition, faculty and career opportunities of this interdisciplinary program. The doctor of philosophy (phd) in population health sciences (phs) is a cohort based, multidisciplinary degree that provides students with the research and analytical tools needed to tackle a wide range of complex, large scale public health issues. Phd & postdoc opportunities by field explore phd and postdoc opportunities across top academic fields. browse research areas in engineering, computer science, health sciences, social sciences, business, and the humanities. A phd in health sciences and the doctor of health science (dhsc) degree are both advanced degrees in the field of health sciences, but they have different focuses and outcomes. Explore the top online phd in health sciences programs for 2026. find accelerated classes and fast online degrees to advance your career in healthcare. Find a phd is a comprehensive guide to phd studentships and postgraduate research degrees.
Phd In Health Sciences Engineering Icahn School Of Medicine Phd & postdoc opportunities by field explore phd and postdoc opportunities across top academic fields. browse research areas in engineering, computer science, health sciences, social sciences, business, and the humanities. A phd in health sciences and the doctor of health science (dhsc) degree are both advanced degrees in the field of health sciences, but they have different focuses and outcomes. Explore the top online phd in health sciences programs for 2026. find accelerated classes and fast online degrees to advance your career in healthcare. Find a phd is a comprehensive guide to phd studentships and postgraduate research degrees.

Applied Health Sciences Phd Degree Program Explore the top online phd in health sciences programs for 2026. find accelerated classes and fast online degrees to advance your career in healthcare. Find a phd is a comprehensive guide to phd studentships and postgraduate research degrees.
Comments are closed.